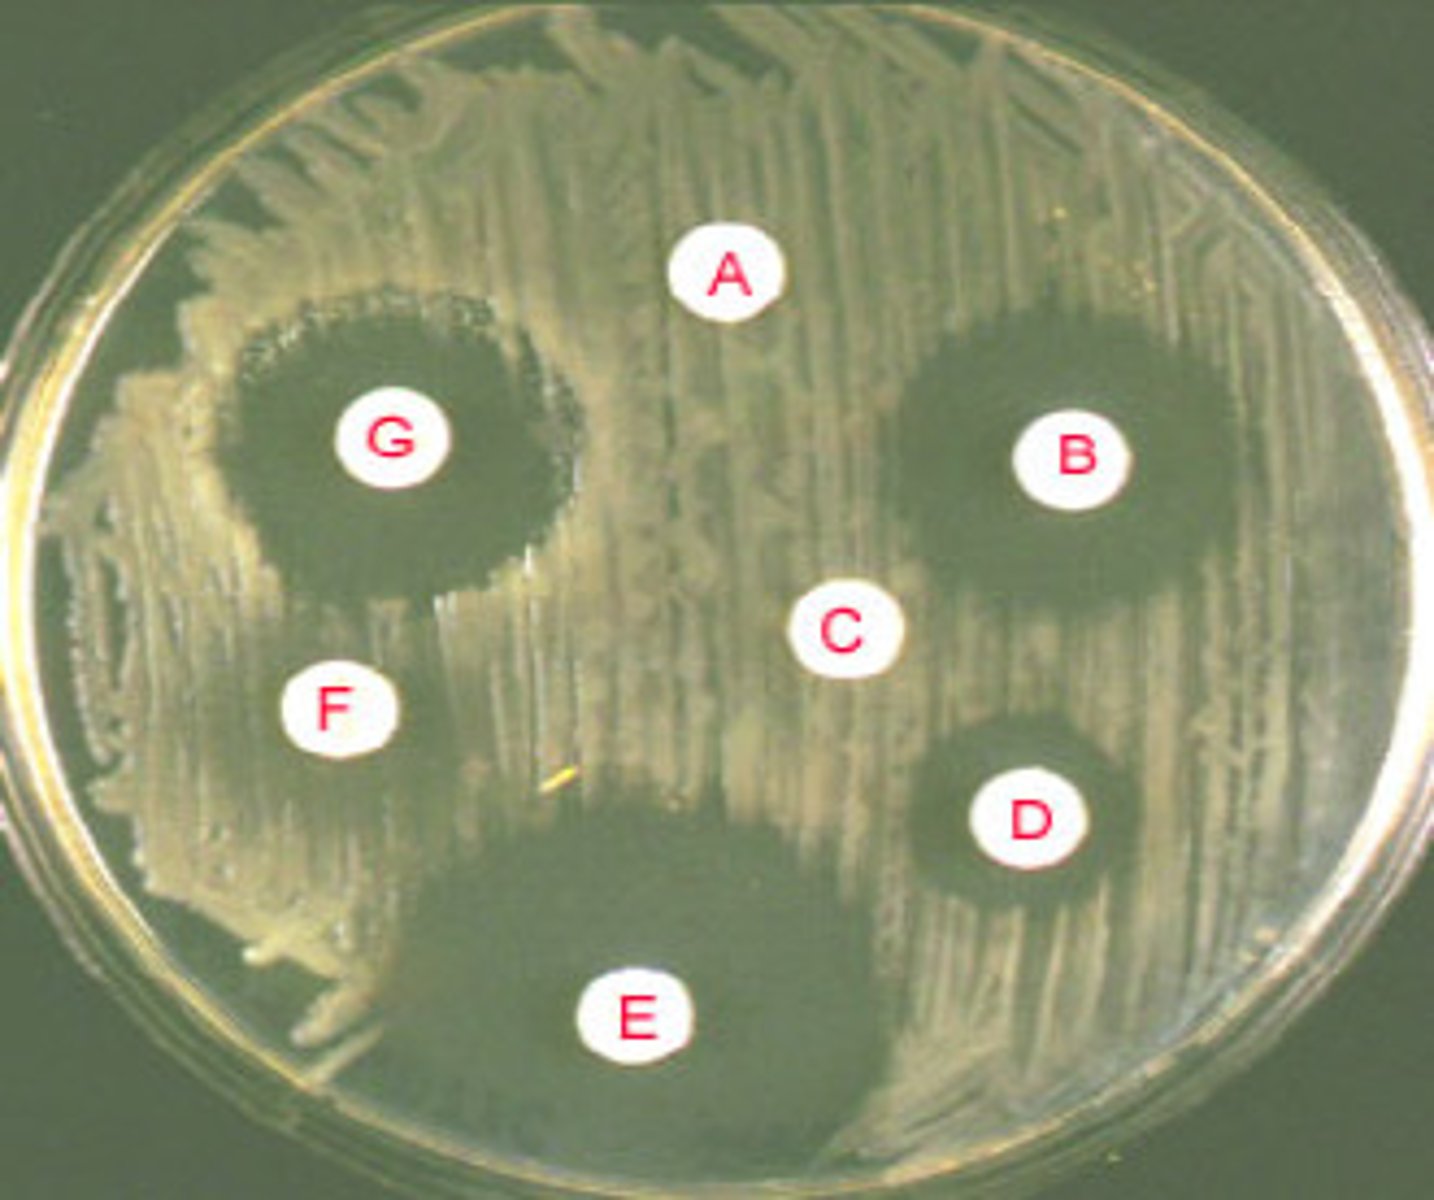
<p>- based on culture results &amp; sensitivity information (best tx)</p><p>- empiric tx maybe switched to focal ('focused') tx ('advancing care')</p><p>- drug must reach target (PKPD - imperative!)</p><p>- admin route &amp; distribution considerations: PKPD (eg. BBB, bone, joints, testes)</p><p>- compliance with treatment</p>

L17: Infection, Sepsis & Shock
1/91
There's no tags or description
Looks like no tags are added yet.
Name | Mastery | Learn | Test | Matching | Spaced | Call with Kai |
|---|
No study sessions yet.
92 Terms
What is the difference between innate and acquired immunity
- innate = born with (includes: physical barriers/WBCs)
- acquired = aka 'humoral/adaptive' (grows over time) (includes: lymphocytes: antibody mediated B memory cells, T memory cells)

How do antibody-mediated B cells work
- activated by an antigen (protein marker on the surface of a pathogen)
- synthesize 'antibodies': serum proteins called 'immunoglobulins' (Ig) (can be given as meds in plasma aka passive immunity)
- antibodies inactivate invading pathogens + mark them for phagocytic destruction

What are the different types of cell-mediated T memory cells
- helper (tags pathogens), cytotoxic (attacks cells), memory, regular/regulatory (regulates immune systems & shuts off pathogenic response)
- note: T cells have high viral efficacy

How does immunity overall work in the body
- immunity becomes established & is long term (due to exposure/immunization)
=> faster response in subsequent exposures (memory cells)
- includes 'passive' immunity (acquired but short term eg. maternal-infant IgA; IVIG infusion)
- note: inflammation's vascular stage - allows for WBC tissue migration

What is our 1st step in infection control
1st step: assessment - where is it & what is the cause? (many pathogens may cause many infections in many parts of the body)
- S&S, port of entry, immunity of the host (eg. vaccinations, chronic illness)
- physical exam & LATERSNAPS

What are the generic/prodromal S&S of infection
- most common: inflammation & pain
- headache, fever, malaise

What is inflammation overall
- an innate, non-specific response
- onset: minutes (acute inflammation)
- triggered by a noxious stimulus (eg. pathogen, allergen, injury)
- inflammatory mediators released from tissue cells (as per the noxious stimulus)

What are the different types of inflammatory/proinflammatory mediators that could be released
- inflammatory: histamine (allergy), prostaglandin (injury), bradykinin, leukotrienes
- pro-inflammatory: complement system, cytokines
- nitric oxide (NO) release (from endothelial cells, WBCs) (synthesized in endothelium & contributes to vasodilation & increased permeability)

What are the 3 overall stages of inflammation
1. vascular stage
2. cellular stage
3. signalling/phagocytosis stage

What is the vascular stage of inflammation
- vasodilation
- increased vascular (and intracellular PRN) permeability

What is the cellular stage of inflammation
- WBC migration into tissue (eg. phagocytes: Neutrophils, Macrophages, NK cells)
- cells move toward the noxious stimulus via margination, transmigration & chemotaxis

What is the signalling/phagocytosis stage of inflammation
- pro-inflammatory mediators attract more WBCs & induce own synthesis
- results in phagocytosis of noxious stimulus

What are mast cells
- very tissue dwelling cell
- responsible for degranulation & release of inflammatory & pro-inflammatory mediators

What are the S&S of chemical mediator release in inflammation (nonspecific)
- vasodilation (redness, heat)
- vascular permeability (edema)
- cellular infiltration (pus)
- thrombosis (clots)
- stimulation of nerve endings (pain)

What is the 2nd step in infection control
2nd step: intervention
- pt & s&s dependant
- consider empiric tx
- acquire more information (eg. culture (eg. CSF collection aka spinal tap), CBC & differential; antibody analysis (eg.antibody titre) if difficult to analyze or culture (e.g. TB))

What disease cannot be culture swabbed
Otitis media (aka middle ear infection): usually seen in children (enclosed infection, therefore cannot swab)

What is the overall source of all blood cells
BONE MARROW

What cells are derived from myeloid precursor cells
eosinophils, neutrophils, monocytes, mast cells, basophils

What are the components that make up blood
- cells aka 'formed elements' = 45%
- plasma = 55% (90% water, 10% solutes)
- buffy coat (platelets - leukocytes & thrombocytes) = <1%

What makes up the 'formed elements' component of blood
- 45% of whole blood volume (includes all cells!)
- synthesized via 'hemopoiesis' (hematopoiesis)
- includes: RBC, WBC, platelets, & leukocytes (eg. neutrophils, lymphocytes)

What makes up plasma in whole blood
- 55% of whole blood volume
- make up: H20 + solutes (eg. electrolytes, nutrients) + blood proteins
- H20: 92% of plasma
- blood proteins: 8% (contribute to the osmolarity of blood)

What makes up blood proteins in plasma
- synthesized primarily in liver
- low if body protein is low (eg. malnutrition, starvation)
- includes: albumins, alpha-1 glycoprotein, fibrinogen, immunoglobulins (Ig), c-reactive proteins

What are the different functions of the blood proteins
- albumins: colloid pressure & drug binding
- fibrinogen: coagulation (precursor for fibrin production)
- Immunoglobulins (Ig), C-reactive protein: immune responses

What are c-reactive proteins overall?
- general marker of inflammation
- increased levels cause inflammation (eg. rheumatoid arthritis => give glucocorticoids & test c-reactive protein levels for efficacy)

How does empiric abx tx work?
- bugs & drugs consult
- based on suspected bacteria & evidence (clinical presentation) (eg. fever)
=> allows us to estimate pathogen + tx decision
- "educated guess" with the info we have
- note: no abx if it's not a bacterial infection (eg. antifungals/antivirals)
- started ASAP, especially if: severe infection/sepsis, exhausted host (don't wait!)

What WBC are most present in bacterial infection
- neutrophils
- band neutrophils may be present in overwhelming response (immature neutrophils)

What cells are most likely to be present in viral infection
lymphocytes (t & b cells)

How do culture results allow us to identify a pathogen & how to tx
bacteria, viruses => classification of bacteria by 'iodine staining'. either:
- gram negative
- gram positive
- tx via 'focal tx' - abx admin as per culture results

What are the main gram negative bacterium
- E-coli
- Klebsiella, Pseudomonas, Salmonella
- Hib, Cholera, Syphilis
- Gonorrhea, Neisseria M.

What are the main gram positive bacterium
- Staphylococci, Streptococci (Pneumococci)
- Enterococci
- Listeria, C-diff

How does focal treatment work
- based on culture results & sensitivity information (best tx)
- empiric tx maybe switched to focal ('focused') tx ('advancing care')
- drug must reach target (PKPD - imperative!)
- admin route & distribution considerations: PKPD (eg. BBB, bone, joints, testes)
- compliance with treatment
What is the current tx recommendation for C-diff?
- flagyl (metronidazole)
- vancomycin
- probiotics (Bio K+)
always PO!

What are the different categories of abx
- cell wall synthesis inhibitors (bactericidal, causes cell lysis)
- protein synthesis inhibitors
- antimetabolites (inhibits enzymatic & synthesis of metabolites)
- nucleic acids inhibitors (inhibits DNA replication & transcription)

What are the cell wall synthesis inhibitors (classes)
- penicillins
- cephalosporins
- bacitracin
- vancomycin
- carbapenems

What are the protein synthesis inhibitors (classes)
- chloramphenicol
- erythromycin
- tetracyclines
- streptomycin

What are the antimetabolites (classes)
- sulfanilamide
- trimethoprim

What are the nucleic acid inhibitors (classes)
- quinolones
- rifampin

What are the general s/e of abx
- GI: diarrhea, abdominal pain, nausea
- opportunistic infections (eg. C-diff yeast, broader spectrum Abx/long duration)
- drug-drug interactions (eg. abx & oral contraceptives)
- allergic reactions (penicillins/cephalosporins/sulfanilamides)
- antibiotics may be cytotoxic, need to assess levels in blood

What is the difference between hives & papules (allergy vs sensitivity)
- hives: allergic rxn, d/t overdrive histamine response
- papules: NOT an allergy, it is a sensitivity (not histamine driven), very common, seen in 3-10 days of abx tx

What is the main allergic responses to abx
- allergy is within 15 mins of exposure (seen after 1-2 doses of abx)
- hives (NOT papules)
- allergy s&s: runny nose, watery eyes, angioedema, facial swelling

What is immunotherapy
- alternate tx from abx, not pathogenocytic (destroying pathogens)
- supplement host's immunity & boosts it
- high efficacy: some viral infections, immunosuppressed pts, chronic illnesses

How are cytokines used in immunotherapy
- cytokines such as: interferons, interleukins
- immune mediators (synthetic drugs - NOT biologics)
- stimulate immune system (eg. WBC synthesis, T-cell stimulation, phagocytosis)
- high efficacy: viral infections, HIV
- route: IV (most common)
- drugs, eg: Avonex (interferon 1a)

How are immunoglobulins (Ig) used in immunotherapy
- antibodies (donor acquired, therefore "biologics")
- immediate 'immunity boost' (passive immunity - short term protection)- route: IV (most common)
- drugs, eg: IVIG (intravenous immunoglobulin)

What is the primary way to prevent infection
- immunization!!
- administration of antigen (dead; alive & weakened 'attenuated'; signaling eg. mRNA)=> triggers synthesis of antibodies by B cells
- boosters to increase recognition (up to 99% protection)
- high efficacy for bacterial & viral infections (eg. COVID19, Meningococcus, Polio, TB, etc)

what was the 1st successful immunization
- Smallpox (virus)
- mortality (30%); hemorrhagic smallpox (97%)
- multi-organ failure
- vaccine => complete eradication of disease

How is a fetus/newborn considered 'immunodeficient'
'passive' immunity
- transfer of IgG (immunoglobulin gamma) during pregnancy (via placenta), most during last few weeks of gestation
- transfer of IgA in breast milk => protect GI against newborn intestinal infections

How are elderly considered 'immunodeficient'
- decreased WBC fx
- decreased specificity of cells:
- B-cells => decreased differentiation leading to misdiagnosis of self = risk of more autoimmune diseases
- T-cells (Thymus gland: T cell differentiation & maturation), declining #s since adolescence

What are all of the overall tx options for infection
- antiinfectives: eg. antibiotics (abx), antifungals (direct elimination of pathogen or its virulence)
- immunotherapy: eg. IVIG (supplementation with immune agents (eg. IgG))
- immunizations: stimulates antibody synthesis (eg. IgG) (preventative)
- surgery => removal of infected tissue or infectious agents (eg. excision, wound debridement, abscess drainage)

How does infection trigger inflammation
- infection: noxious stimulus => acute inflammation (begins within minutes)
- lasts: < 10 days (chronic inflammation causes organ dysfunction & necrosis)
- goal: eliminate causative agent & injured tissue, begin tissue repair

What does inflammatory response activate in infection (cellular level)
- endothelial cells, mast cells, inflammatory mediators; macrophages
- other WBC & chemotaxis; pro-inflammatory mediators; platelets
- fever

What can chronic inflammation cause
- d/t repetitive inflammation
- causes dysfunction of the affected part of the body
- results in proliferation & therefore scarring d/t constant overwhelming response

What are the different aspects of immune response
- general to specific: innate response (innate immunity)/antigen specific response (acquired immunity)
- local to systemic: local = inflammation at the site/systemic = inflammatory response is overwhelming/systemic
- infection-inflammation continuum, monitor!
- can go from local to systemic very fast
- infection => sepsis => septic shock

What is sepsis
- 'infection from ANY body part that causes an extreme inflammatory response & organ hypoperfusion => life threatening'
- infection is in: blood (septicemia/bacteremia) OR in tissue (within an organ)
- hypoperfusion: d/t vasodilation (systemic inflammation)
- ALWAYS an emergency, progresses to septic shock if untreated
- not 'staged'
- tx as per protocol, if hypoperfusion persists: septic shock dx

What is the main etiology of sepsis
- any pathogen can cause it
- respiratory infections = 50% of cases
- IV line contamination

What is distributive shock
- 3 types, all marked by a massive inflammatory response
- causes vasodilation & hypotension
- look for compensation such as tachycardia, or decompensation such as bradycardia

What are the types of distributive shock
3 types: marked by excessive inflammation
1. Septic (response to a pathogen)
2. Anaphylactic (response to an allergen)
3. Neurogenic (response to an injury)

What happens in distributive shock
- overwhelming inflammatory response
- vasodilation => low volume for the size of the circulatory compartment => fluid shift
- aka 'vasodilatory shock', 'normovolemic shock'
- loss of blood vessel tone & enlargement of vessel lumen - insufficient BP for perfusion
- no absolute loss of blood BUT redistributed via vessel permeability, therefore low
vascular volume

What is septic shock
- exaggerated immune response to infection
- 'presence of ongoing hypotension & acidosis in a septic patient'
- hypotension persists despite IV fluids & vasopressors
- less perfusion & oxygen to tissues, anaerobic respiration produces: lactic acid & serum lactate, causing acidosis (serum lactate > 2)

What happens in septic shock
- hypotension => hypoxia + hypoxemia => overall ischemia - leads to:
- renal failure, DIC, metabolic acidosis, hyperglycemia
- high mortality risk

What is occult septic shock
- 'hidden' symptoms => no obvious sign of infection (eg. no fever)
- easier to mis-diagnose, pay attention to health hx, chief concern, VS

What is cyanosis septic shock
- bluish tinge to body, sign of low oxygenation of tissues
- d/t many factors, can either be peripheral or central cyanosis
- both types of cyanosis can be present in severely ill patients (eg. sepsis - peripheral cyanosis, eg. septic shock - progresses to central cyanosis)

What is the difference between peripheral & central cyanosis in septic shock
- peripheral cyanosis: low peripheral perfusion (eg. low CO, peripheral vasoconstriction - eg. cold, shock)
- central cyanosis: deoxygenated hemoglobin, never normal (eg. acidosis, high CO2) => increasing CO2 & low O2 => more difficult for Hgb to bind O2 molecules!!!!

What is mottled septic shock
- uneven appearance to skin, sign of low perfusion
- spidery look to vessels on skin (red)
- eg. with low CO, can happen in MI (most check troponin levels to rule out an MI)

How would we tx septic shock via IV fluid resuscitation
- LR 500 mL bolus & reassess (preferred over NS)
- (peds: 20 mL/kg) assess: LOC, urine output, skin, pulses

What happens if we use NS for fluid resuscitation in septic shock
- risk of increase metabolic acidosis (why it is not 1st line tx choice)
- chloride causes renal vasoconstriction & reduces renal perfusion

How are 'pressors' used for septic shock tx
- aka adrenergics/catecholamines/inotropes, IV
- used to bring MAP above 65mmHg
- norepinephrine: efficacious for alpha receptors to vasoconstrict, use LR to alkalize
- vasopressin (ADH): decreases urine output & increases BP (foley insert to measure urine output)

What are other forms of tx in septic shock
- abx: empiric => focal (eg. vancomycin - do not push fast, or pip/taz combo)
- O2: by mask => intubate PRN, maintain >92% saturation
- source control: surgery (eg. appendectomy)
- analgesia: tylenol, NSAIDs (ibuprofen), opioids
- isolation precautions

What is the best defense against sepsis & septic shock via abx
- empiric antimicrobial therapy
- speed is life => started within 1 hour, tx right away!
- in septic shock: mortality rises @ 10% per hour without abx tx
- overall mortality in septic shock: up to 80%
=> culture to confirm (specificity)
- caution: blood culture has up to 70% failure rate d/t no bacteremia with all sepsis

How can renal failure arise in septic shock and its s&s
- d/t hypotension & organ hypoperfusion => renal ischemia
- normal renal flow: 20% of CO => renal fx affected within 15-20 min of ischemia
- S&S: oliguria (< 0.5mL/kg/hr) (too little urine output => need adequate perfusion to produce filtrate & increase fluids & vasoconstriction of vessels)

How to tx renal failure in septic shock
Tx: catecholamines (low dose), IV fluid resuscitation (we are currently too vasodilated, therefore vasoconstrictors are used)

What is normal pH regulation
- normal pH: 7.35-7.45
- balance between bicarbonate & hydrogen ions (H+)
- renals allow for adequate pass of byproducts (lactate) to level out pH

What organs take part in pH regulation
1. intracellular - oxygen used for cellular function, byproducts: CO2 & H20
2. lungs (eliminate CO2)
3. renals (excrete H+ & reabsorb bicarbonate)

How can pH fail to regulate (acidosis as a result)
1. intracellular: cellular hypoxia results in anaerobic cellular metabolism => byproduct: lactic acid
- inflammatory reactions increase anaerobic metabolism => lactic acid
2. lungs: hypoperfusion=low oxygenation & ventilation => low O2 & high CO2
3. renals: renal hypoperfusion leads to decreased renal clearance of H+ (acidic) => acidosis

What are the 2 types of metabolic acidosis
2 types: lactic acidosis & ketoacidosis
- lactic acidosis: elevated serum lactate, a result of tissue hypoxia
- potassium will increase in blood and decrease in cells
- high levels of chloride
- give insulin
- get a complete ABG (arterial blood gases) to identify acidosis
What are the s&s of metabolic acidosis
- headache, decreased LOC
- hypotension, hyperkalemia
- muscle twitching
- warm/flushed skin
- N&V, diarrhea
- kussmaul resps (compensatory hyperventilation)

How to tx metabolic acidosis
- check ABGs & blood pH
- tx of underlying cause (eg. infection)
- O2: optimize oxygenation & ventilation (increase ventilation to decrease CO2)
- electrolytes: check & correct (eg. hyperkalemia d/t potassium shift from cells)
- sodium bicarbonate admin (adjunct)

Why do we admin sodium bicarbonate in metabolic acidosis
- neutralizes environment, adjunct tx
- ***not always indicated (eg. can cause hyperosmolarity)
- *does not tx underlying cause (essentially puts a 'bandaid' on pH)

What happens in hyperglycemia
- tissue hypoxia => decreased cellular metabolism & transport of glucose to cells
- pro-inflammatory mediators released => decrease insulin efficacy => high BG

How can stress cause hyperglycemia
stress situation => neuroendocrine stimulation
=> release of catecholamines & cortisol => SNS activation & hepatic glucose production (gluconeogenesis and glycogenolysis) => hyperglycemia
- ***survival mechanism

How to tx hyperglycemia
- tx: insulin IV; enteral nutrition (NG feed to prevent hypoglycemia and preserve GI fxn)
- parenteral causes further fluid shift

What are the s&s of GI ischemia
- due to SNS activated vasoconstriction, s&s:
- N&V
- abdominal pain
- if not stopped, may cause: bowel necrosis, hemorrhaging

How to tx GI ischemia
- NG feed to preserve fx (eliminating reflux)
- PPIs, H2 receptor antagonists to decrease GI acidity
- antiemetics (make pt comfortable)

What are Proton Pump Inhibitors (PPIs)
- bind to H/K-ATPase enzymes to inhibit the proton pump and prevent HCl acid secretion
- drugs: Omeprazole (Losec), Iansoprazole (Prevacid), Pantoprazole (Pantoloc)
- higher efficacy and longer half-life (t1/2) than H2 receptor antagonists
- for long term use and chronic relief

What drugs are PPIs that may be used to tx GI ischemia?
Omeprazole (Losec), Iansoprazole (Prevacid), Pantoprazole (Pantoloc)

What are H2 receptor antagonists (blockers)
- histamine 2 receptor antagonism, selective H2 specific blockade that decreases HCL (Ach and gastrin still present)
- drugs: Ranitidine (Zantac) which does not cross BBB, Cimetidine (Tagamet), Famotidine (Pepcid)
- quick relief for acute tx

What drugs are H2 receptor antagonists that may be used to tx GI ischemia?
Ranitidine (Zantac), Cimetidine (Tagamet), Famotidine (Pepcid)

What is disseminated intravascular coagulation (DIC)
- activation of coagulation via tissue injury
- stimulates endothelial cells, platelets, inflammatory mediators
- decreased hepatic perfusion due to shock => decreased plasmin for clot lysis & decreased coagulation factor formation

What are the stages of DIC
=> 1st: widespread coagulation
=> 2nd depletion of platelets & clotting factors => bleeding

How to tx DIC
- stage dependent, may include:
- anticoagulants: Heparin, LMWHs (Enoxaparin, Dalteparin, Apixiban)
- blood products (whole blood; platelets; Vit K)

What is the cause of fever
- innate immunity 'process' barrier
- response to high cytokines & pyrogens

How can an infection progress to shock
- serious, progresses fast
- high morbidity/mortality rates
- eg. bacterial meningitis (eg. Neisseria meningitidis) => may not have s&s of meningitis! may develop rash first!

How must we assess the integument in an infection
- is there a rash? when did it start?
- what is the distribution, what does it look like?
petechial rash = bleeding (what is occurring internally?)
